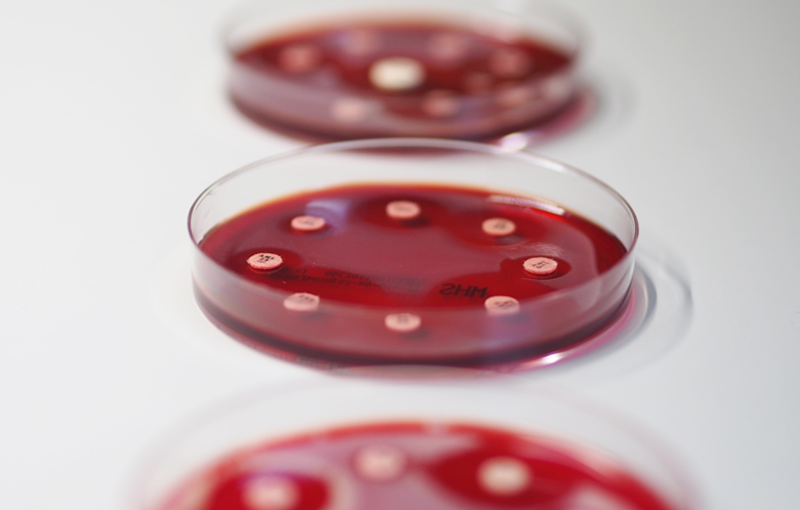
Petrischalen mit Versuchen

KONTAKT
TIERÄRZTLICHE GEMEINSCHAFTSPRAXIS
FÜR SCHWEINE UND GEFLÜGEL
Nehmen Sie gerne Kontakt mit uns auf. Rufen Sie an oder schreiben Sie uns.
Wir freuen uns auf Ihre Anfrage!
Standort Kreis Gütersloh
Otto-Hahn-Str. 22
33442 Herzebrock-Clarholz
Telefon: 05245 5161
Fax: 05245 5162
info@tgp-sug.de
Bürozeiten:
Montag-Freitag
08:00 – 18:00 Uhr
Standort Kreis Soest
Dinker Berg 11
59514 Welver
Telefon: 02384 14 22
Fax: 02384 55 90
info@tapdinker.de
Bürozeiten:
Montag-Freitag
08:00 – 18:00 Uhr

Tierärztliche Gemeinschaftspraxis
für Schweine und Geflügel
info@tgp-sug.de
Standort Kreis Gütersloh
Otto-Hahn-Str. 22
33442 Herzebrock-Clarholz
Telefon: 05245 5161
Fax: 05245 5162
Standort Kreis Soest
Dinker Berg 11
59514 Welver
Telefon: 02384 1422
Fax: 02384 5590